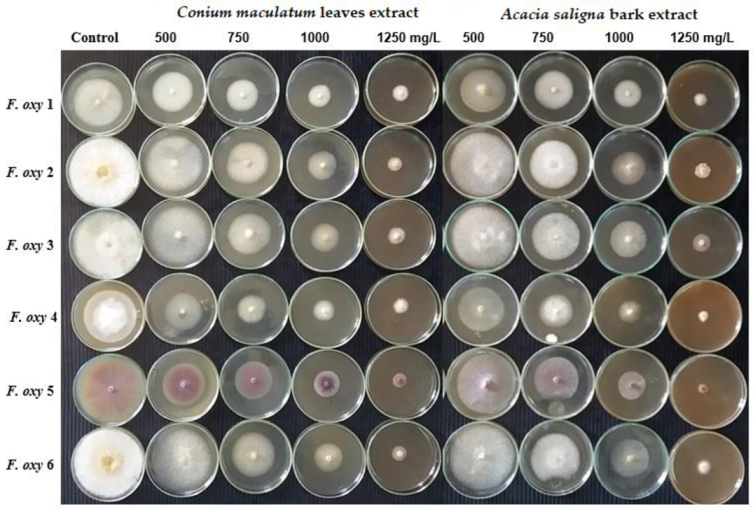
Plants 10 01325 g002a Plants 10 01325 g002a
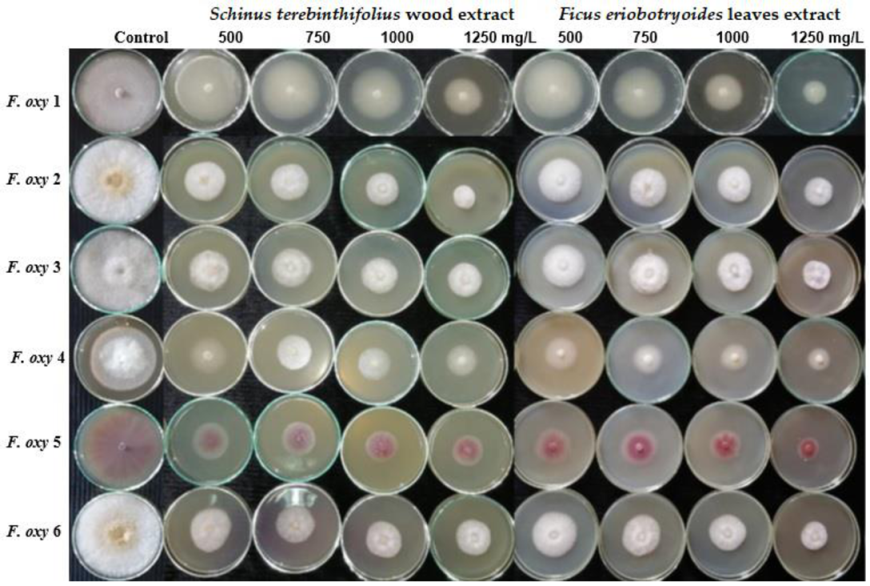
Plants 10 01325 g002b Plants 10 01325 g002b

Characterization of Phytoconstituents from Alcoholic Extracts of Four Woody Species and Their Potential Uses for Management of Six Fusarium oxysporum Isolates Identified from Some Plant Hosts
Abstract
1. Introduction
2. Materials and Methods
2.1. Extraction of Plant Materials
2.2. Phenolic and Flavonoid Compositions of Plant Extracts by HPLC Analysis
- (A)
- HPLC grade water 0.2% H3PO4 (v/v)
- (B)
- methanol
- (C)
- acetonitrile
2.3. Antifungal Activity and Minimum Inhibitory Concentration (MIC) Assays of Four Plant Extracts
2.4. Antioxidant Activity of the Extracts
2.5. Statistical Analysis
3. Results
3.1. Phytochemical Analysis of Extracts by HPLC
3.2. Antifungal Activity of Extracts
3.3. Antioxidant Activity of Extracts
4. Discussion
5. Conclusions
Author Contributions
Funding
Informed Consent Statement
Data Availability Statement
Acknowledgments
Conflicts of Interest
References
- Mansour, M.M.A.; Abdel-Megeed, A.; Nasser, R.A.; Salem, M.Z.M. Comparative evaluation of some woody tree methanolic extracts and Paraloid B-72 against phytopathogenic mold fungi Alternaria tenuissima and Fusarium culmorum. BioResources 2015, 10, 2570–2584. [Google Scholar] [CrossRef]
- Mansour, M.M.A.; Salem, M.Z.M. Evaluation of wood treated with some natural extracts and Paraloid B-72 against the fungus Trichoderma harzianum: Wood elemental composition, in-vitro and application evidence. Int. Biodeterior. Biodegrad. 2015, 100, 62–69. [Google Scholar] [CrossRef]
- Al-Huqail, A.A.; Behiry, S.I.; Salem, M.Z.M.; Ali, H.M.; Siddiqui, M.H.; Salem, A.Z.M. Antifungal, antibacterial, and antioxidant activities of Acacia saligna (Labill.) HL Wendl. flower extract: HPLC analysis of phenolic and flavonoid compounds. Molecules 2019, 24, 700. [Google Scholar] [CrossRef] [PubMed]
- Ashmawy, N.A.; Salem, M.Z.M.; El Shanhorey, N.; Al-Huqail, A.A.; Ali, H.M.; Behiry, S.I. Eco-friendly wood-biofungicidal and antibacterial activities of various Coccoloba uvifera L. leaf extracts: HPLC analysis of phenolic and flavonoid compounds. BioResources 2020, 15, 4165–4187. [Google Scholar]
- Salem, M.Z.M.; Mervat, E.-H.; Nasser, R.A.; Ali, H.M.; El-Shanhorey, N.A.; Elansary, H.O. Medicinal and biological values of Callistemon viminalis extracts: History, current situation and prospects. Asian Pac. J. Trop. Med. 2017, 10, 229–237. [Google Scholar] [CrossRef]
- Ashmawy, N.A.; Al Farraj, D.A.; Salem, M.Z.M.; Elshikh, M.S.; Al-Kufaidy, R.; Alshammari, M.k.; Salem, A.Z.M. Potential impacts of Pinus halepensis Miller trees as a source of phytochemical compounds: Antibacterial activity of the cones essential oil and n-butanol extract. Agrofores. Syst. 2020, 94, 1403–1413. [Google Scholar] [CrossRef]
- Abdelsalam, N.R.; Salem, M.Z.M.; Ali, H.M.; Mackled, M.I.; EL-Hefny, M.; Elshikh, M.S.; Hatamleh, A.A. Morphological, biochemical, molecular, and oil toxicity properties of Taxodium trees from different locations. Ind. Crop. Prod. 2019, 139, 111515. [Google Scholar] [CrossRef]
- El-Sabrout, A.M.; Salem, M.Z.M.; Bin-Jumah, M.; Allam, A.A. Toxicological activity of some plant essential oils against Tribolium castaneum and Culex pipiens larvae. Processes 2019, 7, 933. [Google Scholar] [CrossRef]
- Behiry, S.I.; Okla, M.K.; Alamri, S.A.; EL-Hefny, M.; Salem, M.Z.M.; Alaraidh, I.A.; Ali, H.M.; Al-Ghtani, S.M.; Monroy, J.C.; Salem, A.Z.M. Antifungal and antibacterial activities of Musa paradisiaca L. peel extract: HPLC analysis of phenolic and flavonoid contents. Processes 2019, 7, 215. [Google Scholar] [CrossRef]
- EL-Hefny, M.; Salem, M.Z.M.; Behiry, S.I.; Ali, H.M. The Potential Antibacterial and Antifungal Activities of Wood Treated with Withania somnifera Fruit Extract, and the Phenolic, Caffeine, and Flavonoid Composition of the Extract According to HPLC. Processes 2020, 8, 113. [Google Scholar] [CrossRef]
- Stanković, M.S.; Stefanović, O.; Čomić, L.; Topuzović, M.; Radojević, I.; Solujić, S. Antimicrobial activity, total phenolic content and flavonoid concentrations of Teucrium species. Cent. Eur. J. Biol. 2012, 7, 664–671. [Google Scholar] [CrossRef]
- Ruan, Y.; Kotraiah, V.; Straney, D.C. Flavonoids stimulate spore germination in Fusarium solani pathogenic on legumes in a manner sensitive to inhibitors of cAMP-dependent protein kinase. Mol. Plant Micr. Interact. 1995, 8, 929–938. [Google Scholar] [CrossRef]
- Rhouma, A.; Daoud, H.B.; Ghanmi, S.; Salah, H.B.; Romdhane, M.; Demak, M. Antimicrobial activities of leaf extracts of Pistacia and Schinus species against some plant pathogenic fungi and bacteria J. Plant Path. 2009, 91, 339–345. [Google Scholar]
- El Hadrami, A.; Adam, L.R.; Daayf, F. Biocontrol treatments confer protection against Verticillium dahliae infection in potato by inducing anti-microbial metabolites. Mol. Plant Microbe Interact. 2011, 24, 328–335. [Google Scholar] [CrossRef]
- Panter, K.E.; Gardner, D.R.; Shea, R.E.; Molyneux, R.J.; James, L.F. Toxic and teratogenic piperidine alkaloids from Lupinus, Conium and Nicotiana species. In Toxic Plants and Other Natural Toxicants; Garland, T., Barr, A.C., Eds.; Biddle Ltd.: Wallingford, UK, 1998. [Google Scholar]
- Gebhardt, Y.; Witte, S.; Forkmann, G.; Lukačin, R.; Matern, U.; Martens, S. Molecular evolution of flavonoid dioxygenases in the family Apiaceae. Phytochemistry 2005, 66, 1273–1284. [Google Scholar] [CrossRef]
- Harborne, J.B.; Williams, C.A. Flavonoid pattern in the fruits of the Umbelliferae. Phytochemistry 1972, 11, 1741–1750. [Google Scholar] [CrossRef]
- Teubert, H.; Herrmann, K. Flavonol glycosides of leaves and fruits of dill (Anethum graveolens L.). Phenolics and spices. Z. Lebensm. Unters. Forsch. 1978, 167, 101–104. [Google Scholar] [CrossRef]
- Meier, P.; Hotti, H.; Rischer, H. Elicitation of furanocoumarins in poison hemlock (Conium maculatum L.) cell culture. Plant Cell Tissue Organ Cult. (PCTOC) 2015, 123, 443–453. [Google Scholar] [CrossRef]
- Chizzola, R.; Lohwasser, U. Diversity of Secondary Metabolites in Roots from Conium maculatum L. Plants 2020, 9, 939. [Google Scholar] [CrossRef]
- Lòpez, T.N.; Cid, M.S.; Bianchini, M.L. Biochemistry of the hemlock (Conium maculatum L.) alkaloids and their acute and chronic toxicity in livestock. Toxicon 1999, 37, 841–865. [Google Scholar] [CrossRef]
- Razzaghi-Abyaneh, M.; Shams-Ghahfarokhi, M.; Rezaee, M.B.; Jaimand, K.; Alinezhad, S.; Saberi, R.; Yoshinari, T. Chemical composition and antiaflatoxigenic activity of Carum carvi L., Thymus vulgaris and Citrus aurantifolia essential oils. Food Control 2009, 20, 1018–1024. [Google Scholar] [CrossRef]
- Kousar, S.; Rasool, F.; Aafia, S.; Mushtaq, N.; Nazim, N. Evaluation of different botanicals against Verticillium fungicola causal pathogen of dry bubble disease of button mushroom. Pharma Innov. J. 2018, 7, 34–36. [Google Scholar]
- Yanar, Y.; Gökçe, A.; Kadioglu, I.; Çam, H.; Whalon, M. In vitro antifungal evaluation of various plant extracts against early blight disease (Alternaria solani) of potato. Afr. J. Biotechnol. 2011, 10, 8291–8295. [Google Scholar]
- Ali-Shtayeh, M.S.; Al-Assali, A.A.; Jamous, R.M. Antimicrobial activity of Palestinian medicinal plants against acne-inducing bacteria. Afr. J. Microbiol. Res. 2013, 7, 2560–2573. [Google Scholar]
- Ozçelik, B.; Kusmenoglu, Ş.; Turkoz, S.; Abbasoglu, U. Antimicrobial activities of plants from the Apicaceae. Pharm. Biol. 2004, 42, 526–528. [Google Scholar] [CrossRef][Green Version]
- Abdelsalam, N.R.; Ali, H.M.; Salem, M.Z.M.; El-Wakil, H.E. Quantitative and Qualitative Genetic Studies of Some Acacia Species Grown in Egypt. Plants 2020, 9, 243. [Google Scholar] [CrossRef]
- El-Toumy, S.A.; Salib, J.Y.; Mohamed, W.M.; Morsy, F.A. Phytochemical and antimicrobial studies on Acacia saligna leaves. Egypt J. Chem. 2010, 53, 705–717. [Google Scholar]
- Gumgumjee, N.M.; Hajar, A.S. Antimicrobial efficacy of Acacia saligna (Labill.) H.L. Wendl. and Cordia sinensis Lam. leaves extracts against some pathogenic microorganisms. Int. J. Microbiol. Immunol. Res. 2015, 3, 51–57. [Google Scholar]
- Saleem, A.; Ahotupa, M.; Pihlaja, K. Total phenolics concentration and antioxidant potential of extracts of medicinal plants of Pakistan. Z. Naturforsch. C 2001, 56, 973–978. [Google Scholar] [CrossRef]
- Rocha, P.D.S.D.; Paula, V.M.B.; Olinto, S.C.F.; dos Santos, E.L.; de Picoli Souza, K.; Estevinho, L.M. Diversity, Chemical Constituents and Biological Activities of Endophytic Fungi Isolated from Schinus terebinthifolius Raddi. Microorganisms 2020, 8, 859. [Google Scholar] [CrossRef]
- Salem, M.Z.M.; EL-Hefny, M.; Ali, H.M.; Elansary, H.O.; Nasser, R.A.; El-Settawy, A.A.A.; El Shanhorey, N.; Ashmawy, N.A.; Salem, A.Z.M. Antibacterial activity of extracted bioactive molecules of Schinus terebinthifolius ripened fruits against some pathogenic bacteria. Microb. Pathog. 2018, 120, 119–127. [Google Scholar] [CrossRef] [PubMed]
- Hussein, H.S.; Salem, M.Z.M.; Soliman, A.M. Repellent, attractive, and insecticidal effects of essential oils from Schinus terebinthifolius fruits and Corymbia citriodora leaves on two whitefly species, Bemisia tabaci and Trialeurodes ricini. Sci. Hortic. 2017, 216, 111–119. [Google Scholar] [CrossRef]
- Salem, M.Z.M.; El-Shikh, M.S.; Ali, H.M. Antibacterial activity of extract from the stem bark of Schinus terebinthifolius. J. Pure Appl. Microbiol. 2014, 8, 3865–3870. [Google Scholar]
- De Carvalho, M.C.R.D.; Barca, F.N.T.V.; Agnez-Lima, L.F.; de Medeiros, S.R.B. Evaluation of mutagenic activity in an extract of pepper tree stem bark (Schinus terebinthifolius Raddi). Environ. Mol. Mutagenesis 2003, 42, 185–191. [Google Scholar] [CrossRef]
- De Lima Glória, L.; Barreto de Souza Arantes, M.; Menezes de Faria Pereira, S.; de Souza Vieira, G.; Xavier Martins, C.; Ribeiro de Carvalho Junior, A.; Antunes, F.; Braz-Filho, R.; José Curcino Vieira, I.; Leandro da Cruz, L.; et al. Phenolic compounds present Schinus terebinthifolius Raddi influence the lowering of blood pressure in rats. Molecules 2017, 22, 1792. [Google Scholar] [CrossRef]
- Salem, M.Z.M.; Salem, A.Z.M.; Camacho, L.M.; Ali, H.M. Antimicrobial activities and phytochemical composition of extracts of Ficus species: An over view. Afr. J. Microbiol. Res. 2013, 7, 4207–4219. [Google Scholar]
- Hansson, A.; Zelada, J.C.; Noriega, H.P. Reevaluation of risks with the use of Ficus insipida latex as a traditional anthelmintic remedy in the Amazon. J. Ethnopharmacol. 2005, 98, 251–257. [Google Scholar] [CrossRef]
- Manian, R.; Anusuya, N.; Siddhuraju, P.; Manian, S. The antioxidant activity and free radical scavenging potential of two different solvent extracts of Camellia sinensis (L.) O. Kuntz, Ficus bengalensis L. and Ficus racemosa L. Food Chem. 2008, 107, 1000–1007. [Google Scholar] [CrossRef]
- Adeshina, G.O.; Okeke, C.-L.E.; Osuagwu, N.O.; Ehinmidu, J.O. Preliminary in-vitro antibacterial activities of ethanolic extracts of Ficus sycomorus Linn. and Ficus platyphylla Del. (Moraceae). Afr. J. Microbiol. Res. 2010, 4, 598–601. [Google Scholar]
- Abdel-Hameed, E.S.S. Total phenolic contents and free radical scavenging activity of certain Egyptian Ficus species leaf samples. Food Chem. 2009, 114, 1271–1277. [Google Scholar] [CrossRef]
- Atanasova-Penichon, V.; Bernillon, S.; Marchegay, G.; Lornac, A.; Pinson-Gadais, L.; Ponts, N.; Zehraoui, E.; Barreau, C.; Richard-Forget, F. Bioguided isolation, characterization, and biotransformation by Fusarium verticillioides of Maize Kernel compounds that inhibit Fumonisin production. Mol. Plant Microbe Interact. 2014, 27, 1148–1158. [Google Scholar] [CrossRef]
- Xing, F.; Hua, H.; Selvaraj, J.N.; Yuan, Y.; Zhao, Y.; Zhou, L.; Liu, Y. Degradation of fumonisin B1 by cinnamon essential oil. Food Control 2014, 38, 37–40. [Google Scholar] [CrossRef]
- Ploetz, R.C. Fusarium Wilt of Banana. Phytopathology 2015, 105, 1512–1521. [Google Scholar] [CrossRef]
- Postma, J.; Rattink, H. Biological control of Fusarium wilt of Carnation with non-pathogenic isolate of Fusarium oxysporum. Can. J. Botany 1992, 70, 1199–1205. [Google Scholar] [CrossRef]
- Saremi, H. Ecology and Taxonomy of Fusarium species. Ph.D. Thesis, Sydney University, Camperdown, NSW, Australia, 1996. [Google Scholar]
- Tawfik, A.A.; Allam, A.D.A. Improving cumin production under soil infestation with Fusarium wilt pathogen: I-Screening of biocontrol agents. Assiut Univ. Bull. Environ. Res. 2004, 7, 35–44. [Google Scholar]
- Kausar, P.; Chohan, S.; Parveen, R. Physiological studies on Lasiodiplodia theobramae and Fusarium solani, the cause of Shesham decline. Mycopathologia 2009, 7, 35–38. [Google Scholar]
- Windels, C.E. Fusarium species stored in silica gel and soil for ten years. Mycologia 1993, 25, 21–23. [Google Scholar] [CrossRef]
- Vakalounakis, D.J.; Chalkias, J. Survival of Fusarium oxysporum radicis-cucumerinum in soil. Crop Prot. 2004, 23, 871–873. [Google Scholar] [CrossRef]
- Tamuli, P.; Das, J.; Boruah, P. Antifungal Activity of Polygonum hydropiper and Solanum melongena against Plant Pathogenic Fungi. Plant Arch. 2014, 14, 15–17. [Google Scholar]
- Mohamed, A.A.; Behiry, S.I.; Ali, H.M.; EL-Hefny, M.; Salem, M.Z.M.; Ashmawy, N.A. Phytochemical Compounds of Branches from P. halepensis Oily Liquid Extract and S. terebinthifolius Essential Oil and Their Potential Antifungal Activity. Processes 2020, 8, 330. [Google Scholar] [CrossRef]
- Mohamed, A.A.; EL-Hefny, M.; El-Shanhorey, N.A.; Ali, H.M. Foliar Application of Bio-Stimulants Enhancing the Production and the Toxicity of Origanum majorana Essential Oils Against Four Rice Seed-Borne Fungi. Molecules 2020, 25, 2363. [Google Scholar] [CrossRef]
- Martins, S.; Mussatto, S.I.; Martínez-Avila, G.; Montañez-Saenz, J.; Aguilar, C.N.; Teixeira, J.A. Bioactive phenolic compounds: Production and extraction by solid-state fermentation. A review. Biotechnol. Adv. 2011, 29, 365–373. [Google Scholar] [CrossRef]
- Salem, M.Z.M.; Mansour, M.M.A.; Elansary, H.O. Evaluation of the effect of inner and outer bark extracts of Sugar Maple (Acer saccharum var. saccharum) in combination with citric acid against the growth of three common molds. J. Wood Chem. Technol. 2019, 39, 136–147. [Google Scholar] [CrossRef]
- Singh, R.; Kumari, N.; Nath, G. Free radicals scavenging activity and antimicrobial potential of leaf and fruit extracts of Sapindus mukorossi Gaertn. against clinical pathogen. Int. J. Phytomed. 2016, 8, 22–28. [Google Scholar]
- Rice-Evans, C.; Miller, N.; Paganga, G. Antioxidant properties of phenolic compounds. Trends Plant Sci. 1997, 2, 152–159. [Google Scholar] [CrossRef]
- Latté, K.P.; Kolodziej, H. Antioxidant properties of phenolic compounds from Pelargonium reniforme. J. Agric. Food Chem. 2004, 52, 4899–4902. [Google Scholar] [CrossRef]
- El Hajaji, H.; Lachkar, N.; Alaoui, K.; Cherrah, Y.; Farah, A.; Ennabili, A.; El Bali, B.; Lachkar, M. Antioxidant activity, phytochemical screening, and total phenolic content of extracts from three genders of carob tree barks growing in Morocco. Arab. J. Chem. 2011, 4, 321–324. [Google Scholar] [CrossRef]
- Zhang, X.X.; Shi, Q.Q.; Ji, D.; Niu, L.X.; Zhang, Y.L. Determination of the phenolic content, profile, and antioxidant activity of seeds from nine tree peony (Paeonia section Moutan DC.) species native to China. Food Res. Int. 2017, 97, 141–148. [Google Scholar] [CrossRef]
- Salem, M.Z.M.; Abdel-Megeed, A.; Ali, H.M. Stem wood and bark extracts of Delonix regia (Boj. Ex. Hook): Chemical analysis, antibacterial, antifungal, and antioxidant properties. BioResources 2014, 9, 2382–2395. [Google Scholar] [CrossRef]
- Salem, M.Z.M.; Ali, H.M.; Mansour, M.M.A. Fatty acid methyl esters from air-dried wood, bark, and leaves of Brachychiton diversifolius R. Br: Antibacterial, antifungal, and antioxidant activities. BioResources 2014, 9, 3835–3845. [Google Scholar] [CrossRef]
- Amarante, C.V.T.D.; Souza, A.G.D.; Benincá, T.D.T.; Steffens, C.A. Phenolic content and antioxidant activity of fruit of Brazilian genotypes of feijoa. Pesqui. Agropecu. Bras. 2017, 52, 1223–1230. [Google Scholar] [CrossRef]
- EL-Hefny, M.; Mohamed, A.A.; Salem, M.Z.M.; Abd El-Kareem, M.S.M.; Ali, H.M. Chemical composition, antioxidant capacity and antibacterial activity against some potato bacterial pathogens of fruit extracts from Phytolacca dioica and Ziziphus spina-christi grown in Egypt. Sci. Hortic. 2018, 233, 225–232. [Google Scholar] [CrossRef]
- Abdel-Megeed, A.; Salem, M.Z.M.; Ali, H.M.; Gohar, Y.M. Brachychiton diversifolius as a source of natural products: Antibacterial and antioxidant evaluation of the extracts of wood branches. J. Pure Appl. Microbiol. 2013, 7, 1843–1850. [Google Scholar]
- Ali, H.M.; Salem, M.Z.M.; Al Sahli, A.A. Performance of antioxidant activity of methanolic extracts from different parts of some tree species using DPPH radical-scavenging assay. J. Pure Appl. Microbiol. 2013, 7, 131–137. [Google Scholar]
- Salem, M.Z.M.; Ali, H.M.; El-Shanhorey, N.A.; Abdel-Megeed, A. Evaluation of extracts and essential oil from Callistemon viminalis leaves: Antibacterial and antioxidant activities, total phenolic and flavonoid contents. Asian Pac. J. Trop. Med. 2013, 6, 785–791. [Google Scholar] [CrossRef]
- Salem, M.Z.M.; Zayed, M.Z.; Ali, H.M.; Abd El-Kareem, M.S.M. Chemical composition, antioxidant and antibacterial activities of extracts from Schinus molle L. wood branch growing in Egypt. J. Wood Sci. 2016, 62, 548–561. [Google Scholar] [CrossRef]
- EL-Hefny, M.; Ashmawy, N.A.; Salem, M.Z.M.; Salem, A.Z.M. Antibacterial activity of the phytochemicals-characterized extracts of Callistemon viminalis, Eucalyptus camaldulensis and Conyza dioscoridis against the growth of some phytopathogenic bacteria. Microb. Pathogen. 2017, 113, 348–356. [Google Scholar] [CrossRef]
- Taha, A.S.; Salem, M.Z.M.; Abo Elgat, W.A.A.; Ali, H.M.; Hatamleh, A.A.; Abdel-Salam, E.M. Assessment of the impact of different treatments on technological and antifungal properties of produced Papyrus (Cyperus papyrus L.) sheets. Materials 2019, 12, 620. [Google Scholar] [CrossRef]
- Hosseinihashemi, S.K.; Anooshei, H.; Aghajani, H.; Salem, M.Z.M. Chemical composition and antioxidant activity of extracts from inner bark of Berberis vulgaris stem. BioResources 2015, 10, 7958–7969. [Google Scholar] [CrossRef]
- Abdelkhalek, A.; Salem, M.Z.M.; Kordy, A.M. Salem, A.Z.M.; Behiry, S.I. Antiviral, antifungal, and insecticidal activities of Eucalyptus bark extract: HPLC analysis of polyphenolic compounds. Microb. Pathog. 2020, 147, 104383. [Google Scholar] [CrossRef]
- Salem, M.Z.M.; Ibrahim, I.H.M.; Ali, H.M.; Helmy, H.M. Assessment the using of natural extracted dyes and pancreatin enzyme for dyeing of four natural textiles: HPLC analysis of phytochemicals. Processes 2020, 8, 59. [Google Scholar] [CrossRef]
- Mansour, M.M.A.; EL-Hefny, M.; Salem, M.Z.M.; Ali, H.M. The Biofungicide Activity of Some Plant Essential Oils for the Cleaner Production of Model Linen Fibers Similar to Those Used in Ancient Egyptian Mummification. Processes 2020, 8, 79. [Google Scholar] [CrossRef]
- Clinical and Laboratory Standards Institute (CLSI). Reference Method for Broth Dilution Antifungal Susceptibility Testing of Filamentous Fungi, Approved Standard, 2nd ed.; CLSI document M38-A2; Clinical and Laboratory Standards Institute: Wayne, PA, USA, 2008. [Google Scholar]
- El-Mougy, N.S. Effect of some essential oils for limiting early blight (Alternaria solani) development in potato field. J. Plant Prot. Res. 2009, 49, 57–61. [Google Scholar] [CrossRef]
- Rahman, M.; Begum, M.; Alam, M. Screening of Trichoderma isolates as a biological control agent against Ceratocystis paradoxa causing pineapple disease of sugarcane. Mycobiology 2009, 37, 277–285. [Google Scholar] [CrossRef]
- Elansary, H.O.; Norrie, J.; Ali, H.M.; Salem, M.Z.M.; Mahmoud, E.A.; Yessoufou, K. Enhancement of Calibrachoa cultivars antioxidant, antifungal, and antibacterial activities using seaweed extracts: Total phenolic, flavonoids and tannins contents. BMC Complement. Altern. Med. 2016, 16, 341. [Google Scholar] [CrossRef]
- Salem, M.Z.M.; Ashmawy, N.A.; Elansary, H.O.; El-Settawy, A.A. Chemotyping of diverse Eucalyptus species grown in Egypt and antioxidant and antibacterial activities of its respective essential oils. Nat. Prod. Res. 2015, 29, 681–685. [Google Scholar] [CrossRef]
- Formagio, A.S.N.; Volobuff, C.R.F.; Santiago, M.; Cardoso, C.A.L.; Vieira, M.D.C.; Valdevina Pereira, Z. Evaluation of antioxidant activity, total flavonoids, tannins and phenolic compounds in Psychotria leaf extracts. Antioxidants 2014, 3, 745–757. [Google Scholar] [CrossRef]
- Djenidi, H.; Khennouf, S.; Bouaziz, A. Antioxidant activity and phenolic content of commonly consumed fruits and vegetables in Algeria. Prog. Nutr. 2020, 22, 224–235. [Google Scholar]
- Amiri, H. Chemical Composition and Antioxidant Activity of Essential Oil and Methanolic Extracts of Ferula microcolea (Boiss.) Boiss (Apiaceae). Int. J. Food Prop. 2014, 17, 722–730. [Google Scholar] [CrossRef]
- SAS. Users Guide: Statistics (Release 8.02); SAS Institute Inc.: Cary, NC, USA, 2001. [Google Scholar]
- Rongai, D.; Pulcini, P.; Pesce, B.; Milano, F. Antifungal activity of some botanical extracts on Fusarium oxysporum. Open Life Sci. 2015, 10, 409–416. [Google Scholar] [CrossRef]
- Al-Barwani, F.M.; Eltayeb, E.A. Antifungal compounds from induced Conium maculatum L. plants. Biochem. Syst. Ecol. 2004, 32, 1097–1108. [Google Scholar] [CrossRef]
- Yanar, Y.; Kadioğlu, I.; Gökçe, A.; Demirtas, I.; Gören, N.; Çam, H.; Whalon, M. In vitro antifungal activities of 26 plant extracts on mycelial growth of Phytophthora infestans (Mont.) de Bary. Afr. J. Biotechnol. 2011, 10, 2625–2629. [Google Scholar]
- Parveez, G.; Tasneem, K.; Sahaf, K.A.; Munshi, N.A.; Shahzad, A.; Raja, T.A. Screening of ethanolic extracts of various botanicals against Fusarium pallidoroseum (Cooke) Sacc.-the causal agent of twig blight of mulberry. Indian J. Seric. 2013, 52, 24–28. [Google Scholar]
- Rubanza, C.D.K.; Shem, M.N.; Otsyina, R.; Bakengesa, S.S.; Ichinohe, T.; Fujihara, T. Polyphenolics and tannins effect on in vitro digestibility of selected Acacia species leaves. Anim. Feed Sci. Technol. 2005, 119, 129–142. [Google Scholar] [CrossRef]
- Nakafeero, A.L.; Reed, M.; Moleele, N.M. Allelopathic potential of five agroforestry trees, Botswana. Afr. J. Ecol. 2007, 45, 590–593. [Google Scholar] [CrossRef]
- El Sissi, H.I.; El Sherbeiny, A.E.A. The flavonoid components of the leaves of Acacia saligna. Qual. Plant. Mater. Veg. 1967, 14, 257–266. [Google Scholar] [CrossRef]
- Thieme, H.; Khogali, A. The occurrence of flavonoids and tannins in the leaves of some African acacia species. Pharmazie 1975, 30, 736–743. [Google Scholar]
- Negi, B.S.; Dave, B.P. In vitro antimicrobial activity of Acacia catechu and its phytochemical analysis. Indian J. Microbiol. 2010, 50, 369–374. [Google Scholar] [CrossRef]
- Khan, A.J.; Zouba, A.A.; Seapy, D.G. Antifungal activity from leaves of Acacia nilotica against Pythium aphanidermatum. J. Agric. Mar. Sci. 1996, 1, 7–11. [Google Scholar] [CrossRef]
- Khoshkholgh-Pahlaviani, M.R.M.; Massiha, A.R.; Issazadeh, K.; Bidarigh, S.; Giahi, M.; Ramtin, M. Evaluation of antifungal activity of methanol extract of Acacia (Anagalis arvensis) leaves and nystatin against Candida albicans in vitro. Zahedan J. Res. Med. Sci. 2013, 15, 39–41. [Google Scholar]
- Rai, S.P.; Prasad, M.S.; Singh, K. Evaluation of the antifungal activity of the potent fraction of hexane extract obtained from the bark of Acacia nilotica. IJSR 2014, 3, 730–738. [Google Scholar]
- Thendral, T.; Lakshmi, T. Antifungal activity of Acacia catechu bark extract against dermatophytes: An in vitro study. J. Adv. Pharm. Edu. Res. 2017, 7, 25–27. [Google Scholar]
- Elansary, H.O.; Szopa, A.; Kubica, P.; Ekiert, H.; Al-Mana, F.A.; Al-Yafrsi, M.A. Antioxidant and biological activities of Acacia saligna and Lawsonia inermis natural populations. Plants 2020, 9, 908. [Google Scholar] [CrossRef] [PubMed]
- Fatima, M.S.K.; Anwar, M.; Rahman, S.; Sajad, M.A. Antifungal activity of crude extracts of stem-bark of Acacia ampliceps Maslin. (Family Leguminosae). Pure Appl. Biol. 2019, 8, 1690–1697. [Google Scholar]
- Hussein Ayoub, S.M. Flavanol molluscicides from the Sudan Acacias. Int. J. Crude Drug Res. 1985, 23, 87–90. [Google Scholar] [CrossRef]
- Biswas, D.; Roymon, M.G. LC/TOF/ESI/MS based detection of bioactive compounds present in leaf and bark extract of Acacia arabica. Recent Res. Sci. Technol. 2013, 5, 37–40. [Google Scholar]
- Badr, J.M.; Shaala, L.A.; Youssef, D.T.A. Loranthin: A new polyhydroxylated flavanocoumarin from Plicosepalus acacia with significant free radical scavenging and antimicrobial activity. Phytochem. Lett. 2013, 6, 113–117. [Google Scholar] [CrossRef]
- Ceruks, M.; Romoff, P.; Fávero, O.A.; Lago, J.H.G. Polar phenolic constituents from Schinus terebinthifolius Raddi (Anacardiaceae)). Química Nova 2007, 30, 597–599. [Google Scholar] [CrossRef]
- Santana, J.S.; Sartorelli, P.; Lago, J.H.G.; Matsuo, A.L. Isolation and evaluation of cytotoxic potential of phenolic derivatives from Schinus terebinthifolius Raddi (Anacardiaceae). Quimica Nova 2012, 35, 2245–2248. [Google Scholar] [CrossRef]
- Salem, M.Z.M.; El-Shikh, M.S.; Ali, H.M. Fatty Acids Constituents of Wood from Schinus terebinthifolius Raddi using GC Analysis. J. Pure Appl. Microbiol. 2014, 8, 205–209. [Google Scholar]
- Uliana, M.P.; Fronza, M.; da Silva, A.G.; Vargas, T.S.; de Andrade, T.U.; Scherer, R. Composition and biological activity of Brazilian rose pepper (Schinus terebinthifolius Raddi) leaves. Ind. Crop. Prod. 2016, 83, 235–240. [Google Scholar] [CrossRef]
- Johann, S.; Sá, N.P.; Lima, L.A.; Cisalpino, P.S.; Cota, B.B.; Alves, T.M.; Siqueira, E.P.; Zani, C.L. Antifungal activity of schinol and a new biphenyl compound isolated from Schinus terebinthifolius against the pathogenic fungus Paracoccidioides brasiliensis. Ann. Clin. Microbiol. Antimicrob. 2010, 9, 1–6. [Google Scholar] [CrossRef]
- de Araujo Gomes, R.B.; de Souza, E.S.; Barraqui, N.S.G.; Tosta, C.L.; Nunes, A.P.F.; Schuenck, R.P.; Ruas, F.G.; Ventura, J.A.; Filgueiras, P.R.; Kuster, R.M. Residues from the Brazilian pepper tree (Schinus terebinthifolia Raddi) processing industry: Chemical profile and antimicrobial activity of extracts against hospital bacteria. Ind. Crop. Prod. 2020, 143, 111430. [Google Scholar] [CrossRef]
- Feuereisen, M.M.; Hoppe, J.; Zimmermann, B.F.; Weber, F.; Schulze-Kaysers, N.; Schieber, A. Characterization of phenolic compounds in Brazilian pepper (Schinus terebinthifolius Raddi) Exocarp. J. Agric. Food Chem. 2014, 62, 6219–6226. [Google Scholar] [CrossRef]
- Camaroti, J.R.S.L.; de Almeida, W.A.; do Rego Belmonte, B.; de Oliveira, A.P.S.; de Albuquerque Lima, T.; Ferreira, M.R.A.; Paiva, P.M.G.; Soares, L.A.L.; Pontual, E.V.; Napoleão, T.H. Sitophilus zeamais adults have survival and nutrition affected by Schinus terebinthifolius leaf extract and its lectin (SteLL). Ind. Crop. Prod. 2018, 116, 81–89. [Google Scholar] [CrossRef]
- da Silva, M.M.; Iriguchi, E.K.; Kassuya, C.A.L.; do Carmo Vieira, M.; Foglio, M.A.; de Carvalho, J.E.; Ruiz, A.L.T.; Souza, K.D.P.; Formagio, A.S. Schinus terebinthifolius: Phenolic constituents and in vitro antioxidant, antiproliferative and in vivo anti-inflammatory activities. Rev. Bras. Farmacogn. 2017, 27, 445–452. [Google Scholar] [CrossRef]
- Hayashi, T.; Nagayama, K.; Arisawa, M.; Shimizu, M.; Suzuki, S.; Yoshizaki, M.; Morita, N.; Ferro, E.; Basualdo, I.; Berganza, L.H. Pentagalloylglucose, a xanthine oxidase inhibitor from a Paraguayan crude drug," Molle-i"(Schinus terebinthifolius). J. Nat. Prod. 1989, 52, 210–211. [Google Scholar] [CrossRef]
- Queires, L.C.S.; Fauvel-Lafève, F.; Terry, S.; De la Taille, A.; Kouyoumdjian, J.C.; Chopin, D.K.; Vacherot, F.; Rodrigues, L.E.A.; Crepin, M. Polyphenols purified from the Brazilian aroeira plant (Schinus terebinthifolius, Raddi) induce apoptotic and autophagic cell death of DU145 cells. Anticancer Res. 2006, 26, 379–387. [Google Scholar]
- Teixeira, D.M.; Patão, R.F.; Coelho, A.V.; da Costa, C.T. Comparison between sample disruption methods and solid–liquid extraction (SLE) to extract phenolic compounds from Ficus carica leaves. J. Chromatogr. A 2006, 1103, 22–28. [Google Scholar] [CrossRef]
- Qin, H.; Zhou, G.; Peng, G.; Li, J.; Chen, J. Application of ionic liquid-based ultrasound-assisted extraction of five phenolic compounds from Fig (Ficus carica L.) for HPLC-UV. Food Anal. Methods 2015, 8, 1673–1681. [Google Scholar] [CrossRef]
- Pande, G.; Akoh, C.C. Organic acids, antioxidant capacity, phenolic content and lipid characterization of Georgia-grown underutilized fruit crops. Food Chem. 2010, 120, 1067–1075. [Google Scholar] [CrossRef]
- Ao, C.; Li, A.; Elzaawely, A.A.; Xuan, T.D.; Tawata, S. Evaluation of antioxidant and antibacterial activities of Ficus microcarpa L. fil. extract. Food Control 2008, 19, 940–948. [Google Scholar] [CrossRef]
- Teixeira, D.M.; Canelas, V.C.; do Canto, A.M.; Teixeira, J.M.G.; Dias, C.B. HPLC-DAD quantification of phenolic compounds contributing to the antioxidant activity of Maclura pomifera, Ficus carica and Ficus elastica extracts. Anal. Lett. 2009, 42, 2986–3003. [Google Scholar] [CrossRef]
- Baldan, V.; Sut, S.; Faggian, M.; Gassa, E.D.; Ferrari, S.; De Nadai, G.; Francescato, S.; Baratto, G.; Dall’Acqua, S. Larix decidua bark as a source of phytoconstituents: An LC-MS study. Molecules 2017, 22, 1974. [Google Scholar] [CrossRef]
- Mierziak, J.; Kostyn, K.; Kulma, A. Flavonoids as important molecules of plant interactions with the environment. Molecules 2014, 19, 16240–16265. [Google Scholar] [CrossRef]
- Orhan, D.D.; Özçelik, B.; Özgen, S.; Ergun, F. Antibacterial, antifungal, and antiviral activities of some flavonoids. Microbiol. Res. 2010, 165, 496–504. [Google Scholar] [CrossRef]
- Johann, S.; Mendes, B.G.; Missau, F.C.; de Resende, M.A.; Pizzolatti, M.G. Antifungal activity of five species of Polygala. Braz. J. Microbiol. 2011, 42, 1065–1075. [Google Scholar] [CrossRef]
- Cushnie, T.P.T.; Lamb, A.J. Antimicrobial activity of flavonoids. Int. J. Antimicrob. Agents 2005, 26, 343–356. [Google Scholar] [CrossRef]
- Hendra, R.; Ahmad, S.; Sukari, A.; Shukor, M.Y.; Oskoueian, E. Flavonoid analyses and antimicrobial Activity of various parts of Phaleria macrocarpa (Sche_) Boerl Fruit. Int. J. Mol. Sci. 2011, 12, 3422–3431. [Google Scholar] [CrossRef]
- Rocha, M.F.G.; Sales, J.A.; da Rocha, M.G.; Galdino, L.M.; de Aguiar, L.; Pereira-Neto, W.D.A.; de Aguiar Cordeiro, R.; Castelo-Branco, D.D.S.C.M.; Sidrim, J.J.C.; Brilhante, R.S.N. Antifungal effects of the flavonoids kaempferol and quercetin: A possible alternative for the control of fungal biofilms. Biofouling 2019, 35, 320–328. [Google Scholar] [CrossRef] [PubMed]

| Compound | Amount (mg/kg Extract) | |||||||
|---|---|---|---|---|---|---|---|---|
| C. maculatum Leaves | A. saligna Bark | S. terebinthifolius Wood | F. eriobotryoides Leaves | |||||
| RT * | Amount | RT | Amount | RT | Amount | RT | Amount | |
| Pyrogallol | 3.165 | 20.57 | - | ND | - | ND | - | ND |
| Quinol | 3.384 | 23.27 | - | ND | 3.384 | 2530.22 | - | ND |
| Gallic acid | 3.762 | 311.32 | 3.304 | 2551.02 | 3.783 | 67.87 | - | ND |
| Catechol | - | ND | - | ND | 5.944 | 732.28 | - | ND |
| p-Hydroxy benzoic acid | 8.433 | 444.37 | - | ND | 8.389 | 233.27 | 7.861 | 1009.20 |
| Caffeine | 9.327 | 50.63 | 9.204 | 106.73 | 9.389 | 267.62 | - | ND |
| Chlorogenic acid | 9.536 | 30.99 | 9.506 | 103.50 | 9.583 | 174.65 | - | ND |
| Vanillic acid | 9.946 | 95.21 | - | ND | 10.059 | 33.97 | - | ND |
| Caffeic acid | - | ND | 10.401 | 53.55 | 10.544 | 302.27 | 10.102 | 157.48 |
| Syringic acid | 10.931 | 18.87 | - | ND | 10.888 | 109.28 | 10.336 | 5.90 |
| Vanillin | 11.454 | 5.71 | 11.883 | 69.46 | 11.841 | 23.92 | - | ND |
| p-Coumaric acid | 13.940 | 81.86 | 13.832 | 8.27 | 13.837 | 3.58 | 13.193 | 0.0935 |
| Ferulic acid | 14.851 | 15.15 | 15.060 | 42.17 | 14.855 | 12.94 | 15.176 | 145.45 |
| Benzoic acid | 15.074 | 342.16 | 15.212 | 1580.32 | 15.218 | 697.73 | - | ND |
| Rutin | 16.316 | 19.93 | 16.757 | 16.15 | 16.678 | 798.29 | 16.365 | 9168.03 |
| Ellagic acid | 17.511 | 5.74 | - | ND | 17.109 | 116.32 | ND | |
| o-Coumaric acid | 17.964 | 5.82 | 17.652 | 11.44 | 18.164 | 139.04 | 17.791 | 2016.93 |
| Salicylic acid | - | ND | - | ND | 19.256 | 78.35 | - | ND |
| Resveratrol | - | ND | - | ND | - | ND | 19.925 | 1156.99 |
| Cinnamic acid | - | ND | - | ND | 20.483 | 7.16 | - | ND |
| Quercetin | - | ND | 21.572 | 37.36 | 21.622 | 315.44 | 21.600 | 314.85 |
| Rosmarinic acid | 22.033 | 117.87 | 21.731 | 49.57 | 22.040 | 187.66 | 22.069 | 574.907 |
| Naringenin | - | ND | - | ND | 22.667 | 1224.904 | - | ND |
| Myricetin | - | ND | - | ND | - | ND | 23.904 | 65.23 |
| Kaempferol | 24.332 | 16.41 | 23.923 | 10.73 | 24.372 | 175.06 | 24.325 | 10.95 |
| Plant Extracts | Conc. (mg/L) | Inhibition Percentage of Fungal Growth (%) | |||||
|---|---|---|---|---|---|---|---|
| F. oxy 1 | F. oxy 2 | F. oxy 3 | F. oxy 4 | F. oxy 5 | F. oxy 6 | ||
| Control a | 0 | 0.00 | 0.00 | 0.00 | 0.00 | 0.00 | 0.00 |
| Positive control b | 200 | 88.9 ± 1.1 | 85.2 ± 0.6 | 79.2 ± 1.7 | 75.8 ± 1.1 | 84.8 ± 0.6 | 82.6 ± 0.6 |
| C. maculatum leaves | 500 | 27.9 ± 1.8 | 12.6 ± 1.1 | 13.7 ± 0.7 | 34.8 ± 1.4 | 40.2 ± 1 | 8.6 ± 1.7 |
| 750 | 41.5 ± 3.4 | 48.4 ± 1.6 | 40.4 ± 0.7 | 44.5 ± 0.9 | 47.5 ± 0.7 | 30.4 ± 2.7 | |
| 1000 | 62.1 ± 2.6 | 57.1 ± 1.4 | 60.2 ± 1 | 68.7 ± 0.5 | 66.9 ± 1 | 58.2 ± 1.7 | |
| 1250 | 79.5 ± 0.3 | 78.8 ± 1 | 84.2 ± 1.4 | 82.1 ± 0.5 | 86.9 ± 0.7 | 87.1 ± 0.4 | |
| A. saligna bark | 500 | 9.4 ± 0.5 | 11.3 ± 2 | 15.3 ± 1.7 | 9.4 ± 0.5 | 13.1 ± 0.4 | 6.2 ± 1.4 |
| 750 | 27.3 ± 0.9 | 33.1 ± 0.4 | 31.7 ± 1.6 | 44.8 ± 1 | 29.7 ± 3.1 | 32.6 ± 0.6 | |
| 1000 | 49.4 ± 3.4 | 58.2 ± 1.6 | 46.6 ± 1.3 | 56.6 ± 1.9 | 62 ± 1.7 | 47.3 ± 0.6 | |
| 1250 | 80 ± 1.5 | 86.4 ± 0.4 | 86.4 ± 0.4 | 84.2 ± 2.1 | 88.4 ± 1.5 | 88.8 ± 0.8 | |
| S. terebinthifolius wood | 500 | 12.6 ± 0.6 | 46.8 ± 1 | 53.5 ± 1 | 30 ± 0.7 | 49.4 ± 0.6 | 49.5 ± 1.7 |
| 750 | 30 ± 3.1 | 52.8 ± 0.4 | 54.8 ± 1.4 | 50.7 ± 2.7 | 55.8 ± 0.3 | 54.6 ± 1.3 | |
| 1000 | 40 ± 0.6 | 59.3 ± 0.6 | 57.3 ± 0.6 | 60.5 ± 0.9 | 62.7 ± 0.9 | 60 ± 0.6 | |
| 1250 | 54.6 ± 1.3 | 73.5 ± 1 | 57.1 ± 0.4 | 61.8 ± 0.4 | 68.7 ± 0.6 | 60.2 ± 0.4 | |
| F. eriobotryoides leaves | 500 | 30 ± 2.9 | 46.6 ± 0.6 | 41.1 ± 1 | 53.1 ± 0.7 | 54.8 ± 1.3 | 46.6 ± 0.6 |
| 750 | 36.4 ± 3.1 | 52.8 ± 0.4 | 53.3 ± 0.6 | 61.3 ± 0.4 | 60.6 ± 1.9 | 56.4 ± 3.1 | |
| 1000 | 52.6 ± 0.6 | 58.4 ± 1.6 | 60.2 ± 1 | 67.94 ± 1.2 | 63.9 ± 1.6 | 59.3 ± 0.6 | |
| 1250 | 73.1 ± 1.9 | 66.6 ± 0.6 | 66.6 ± 0.6 | 76.6 ± 0.4 | 82.9 ± 1.6 | 71.5 ± 1.7 | |
| p-Value | ** | ** | ** | ** | ** | ** | |
| Plant Extracts | Minimum Inhibitory Concentration (MIC mg/L) against F. oxysporum Isolates | |||||
|---|---|---|---|---|---|---|
| F. oxy 1 | F. oxy 2 | F. oxy 3 | F. oxy 4 | F. oxy 5 | F. oxy 6 | |
| Conium maculatum leaves | 125 | 125 | 64 | 32 | 64 | 64 |
| Acacia saligna bark | 125 | 125 | 64 | 64 | 64 | 64 |
| Schinus terebinthifolius wood | 125 | 250 | 250 | 125 | 250 | 250 |
| Ficus eriobotryoides leaves | 125 | 250 | 250 | 125 | 125 | 250 |
| Carbendazim * | 10 | 10 | 5 | 5 | 10 | 10 |
| Extract | Concentration (μg/mL) * | |
|---|---|---|
| DPPH | BCB | |
| Conium maculatum leaves | 3.4 ± 0.1 e** | 4.5 ± 0.1 d |
| Acacia saligna bark | 10.2 ± 0.1 a | 14.3 ± 0.1 a |
| Schinus terebinthifolius wood | 5.12 ± 0.4 c | 6 ± 0.12 b |
| Ficus eriobotryoides leaves | 4.22 ± 0.12 d | 6.07 ± 0.33 b |
| Positive controls | ||
| AA | 7.66 ± 0.5 b | 5.12 ± 0.1 c |
| BHT | 2.4 ± 0.2 f | 2.78 ± 0.1 e |
Publisher’s Note: MDPI stays neutral with regard to jurisdictional claims in published maps and institutional affiliations. |
© 2021 by the authors. Licensee MDPI, Basel, Switzerland. This article is an open access article distributed under the terms and conditions of the Creative Commons Attribution (CC BY) license (https://creativecommons.org/licenses/by/4.0/).
Share and Cite
Salem, M.Z.M.; Mohamed, A.A.; Ali, H.M.; Al Farraj, D.A. Characterization of Phytoconstituents from Alcoholic Extracts of Four Woody Species and Their Potential Uses for Management of Six Fusarium oxysporum Isolates Identified from Some Plant Hosts. Plants 2021, 10, 1325. https://doi.org/10.3390/plants10071325
Salem MZM, Mohamed AA, Ali HM, Al Farraj DA. Characterization of Phytoconstituents from Alcoholic Extracts of Four Woody Species and Their Potential Uses for Management of Six Fusarium oxysporum Isolates Identified from Some Plant Hosts. Plants. 2021; 10(7):1325. https://doi.org/10.3390/plants10071325
Chicago/Turabian StyleSalem, Mohamed Z. M., Abeer A. Mohamed, Hayssam M. Ali, and Dunia A. Al Farraj. 2021. "Characterization of Phytoconstituents from Alcoholic Extracts of Four Woody Species and Their Potential Uses for Management of Six Fusarium oxysporum Isolates Identified from Some Plant Hosts" Plants 10, no. 7: 1325. https://doi.org/10.3390/plants10071325
APA StyleSalem, M. Z. M., Mohamed, A. A., Ali, H. M., & Al Farraj, D. A. (2021). Characterization of Phytoconstituents from Alcoholic Extracts of Four Woody Species and Their Potential Uses for Management of Six Fusarium oxysporum Isolates Identified from Some Plant Hosts. Plants, 10(7), 1325. https://doi.org/10.3390/plants10071325







